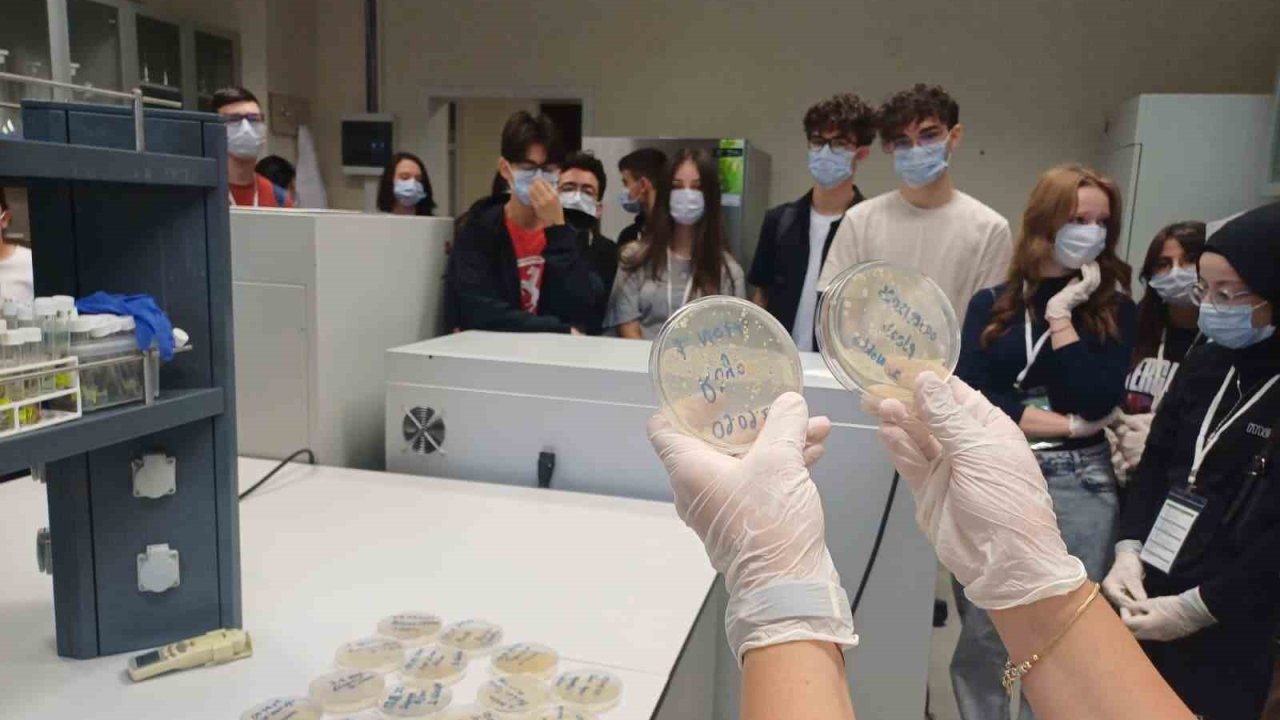
Öğrenciler iklim değişikliğinin etkilerini matematikle öğrendi

Kastamonu'nun Araç ilçesindeki Soğucaova Yaylası sınırlarında yer alan ve doğal güzellikleriyle dikkat çeken bin 700 rakımlı Katbaşı Zirvesi keşfedilmeyi bekliyor. Kastamonu, Çankırı ve Karabük'ü gören zirve, doğal güzelliğiyle mest ediyor.
Kastamonu'nun Araç ilçesindeki yaylaların turizme kazandırılması için çalışmalar sürüyor. Son yıllarda vatandaşların uğrak noktası haline gelen Araç yaylaları, ziyaretçilerini manzaralarıyla mest ediyor. Araç ilçe merkezinden başlayıp 48 kilometrelik mesafede birbirine bağlantılı 33 yaylada, "orman ve tabiat turizmi" alanında ihtisaslaşan Kastamonu Üniversitesi'nce yürüyüş rotası çalışmaları gerçekleştirildi. Bu çerçevede Kastamonu Üniversitesi Öğretim Görevlisi Hikmet Haberal, Ersizlerdere Kalkınma Eğitim ve Eko Turizm Derneği Başkanı Mustafa Çağır ve Kastamonu Doğa Koruma ve Milli Park Müdürlüğü ekipleri Soğucaova Yaylası'nda ve Katbaşı Zirvesi'nde incelemelerde bulundu.
Bin 700 rakımlı Katbaşı Zirvesi'ni bölge halkıyla gezen ekip, Ankara'ya 292 kilometre, İstanbul'a 470 kilometre uzaklıktaki bölgenin turizme kazandırılması için keşif çalışması yaptı. 3 kilometrelik bir mağaranın da yer aldığı bölgede yaşayan yerli halk ise zirve ve yaylanın güzelliğiyle turizm merkezi haline gelebileceğini ifade etti.
"Katbaşı Zirvesi, Çankırı, Kastamonu ve Karabük sınırlarında yer alan doğa harikası bir yer"
Bölgeyle ilgili bilgi veren Kastamonu Üniversitesi Öğretim Görevlisi Hikmet Haberal, "Soğucaova Yaylası'nın 2 kilometre uzaklığında bulunan Katbaşı Zirvesi olarak bilinen bu yer, rakım olarak bin 700 metrededir. Burası görsel güzelliğiyle, tabiat kaynakları açısından önemli bir alan. Bitki çeşitliliği, yaban hayatı çeşitliliği, dağ sarımsakları olan inanılmaz çam ağaçlarının olduğu bir bölge. Katbaşı Zirvesi'nin hemen altında Soğanlı Çayı'nın olduğu Karabük, Kastamonu ve Çankırı sınırlarının 3 ilimizi bir arada göründüğü noktada olan bu doğa harikası bir yer. Buraya insanlar yaylacılık faaliyetleri için geliyorlar ve onlarla da görüştük. Vatandaşlar, piknik amaçlı ve seyir amaçlı gelip burayı görmek istiyorlar. Macera turizmine veya doğal güzellikleri açısından insanların bölgeye gelmesi, bu bölgede gelip çok fazla bir yatırım gerektirmeden bir seyir terası yapılması ve yollarının iyileştirilmesi gerekiyor. Yolun düzenlenmesiyle birlikte hem yerli halk hem de dışarıdan vatandaşlarımız buraya gelecektir. Çünkü burası Karabük, Kastamonu ve Çankırı arasında bulunan bir noktada, insanlarımızın gelip burada seyir yapması, burada piknik yapması önemli katkı sağlayacaktır" dedi.
"Çok fazla yatırım gerektirmeden çok basit kamelya ve seyir terasıyla bölge turizme açılabilir"
Araç ilçesi ile Katbaşı Zirvesi arasında 33 tane yaylanın bulunduğunu belirten Haberal, "Karabük ile Çankırı sınırına doğru Soğucaova Yaylası bulunuyor. Bu bölgeye insanlar stresten, şehirdeki o gürültüden, kalabalık ortamdan uzaklaşıp yaylaya gelebiliyorlar. Soğucaova Yaylası'na gelen vatandaşlarımız, 2 kilometre olan yürüyüş mesafesiyle bu alana gelip burada kendini yenileyebiliyor. En iyi terapi doğal terapidir. Şurada oturup şu manzarayı bir saat izledikten sonra psikiyatriye, psikoloğa gitmezsiniz. Çünkü en iyi terapi budur. Gelip insanların yaylalarda vakit geçirmelerini istiyoruz. Sıradan bir piknik ya da oturma gruplarının yapılması, çardakların yapılmasıyla birlikte buraya da bir seyir terası veya çardak gibi bir kamelya tarzı bir donatıların yapılmasıyla turizme kazandırılabilir. Özellikle Doğa Koruma ve Milli Parklar Müdürlüğü ile Doğa Koruma ve Milli Parklar Genel Müdürlüğü bu işleri çok güzel yapıyor. Bu kurumlarımızın bu bölgelerde bu donatıları yapıp vatandaşların hizmetine sunduğunda bizim bu bölgeye eko turizmin anlamında zaten bu eko turizmin turist tipleri çok farklıdır. Aşırı kalabalık turisti sevmeyen, sakin ve sadeliği seven insanların bölgelere gelmesini istiyoruz. Sayısı az olsun ama gelsin insanlarımız vatandaşlar bu bölgeden faydalansınlar" şeklinde konuştu.
Yöre halkı bölgenin turizme kazandırılmasını istiyor
Emekli olduktan sonra Soğucaova Yaylası'na yerleştiğini belirten Şener Deveci ise, "Katbaşı Zirvesi, yaylamızın sınırları içerisinde olan bir yer. Katbaşı olarak bilinen burasının yüksekliği 2 bin metreye yakındır. Çaykaşı köyünün sınırlarının üstünde oluyor. Yaylaya bağlı bir yer. Bir de mağarayla beraber bağlantısı var. Aynı zamanda aşağısında Soğanlı ve Filyos Çayı üzerinde bulunuyor. Burada paraşüt çalışmaları yapılabilir, gezi yapılabilir, piknik yapılabilir. Bunun dışında doğa turizmi, tabiat turizmine cevap verecek bir ölçüde ve dolayısıyla doğal güzellikleri olan bir yer. Fakat şu ana kadar keşfedilmedi. Tarım ve Orman Bakanlığı ve Kültür ve Turizm Bakanlığı tarafından bu konuda bize yardımcı olmalarını ve bölgenin turizme kazandırılmasını talep ediyoruz" ifadelerini kullandı.
Kaynak:İHA